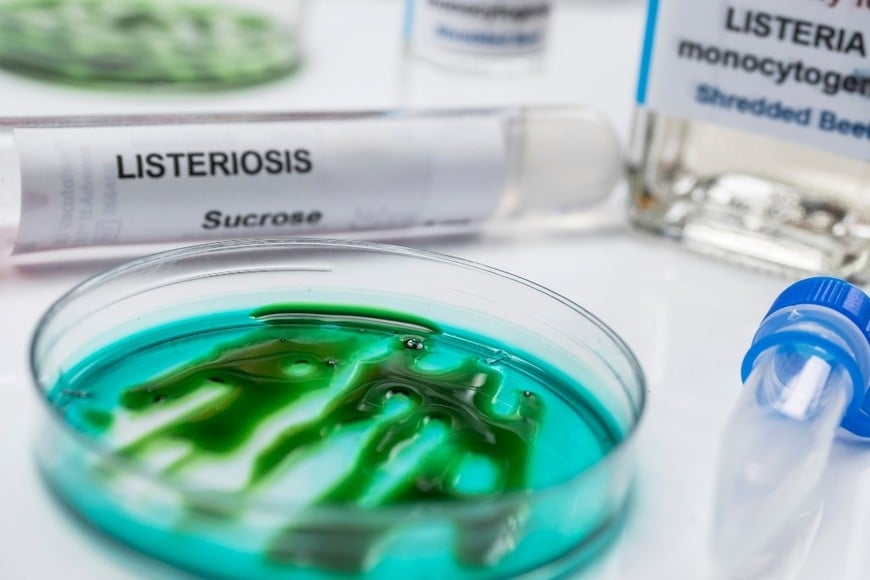
La listeria puede sobrevivir a bajas temperaturas y representar un riesgo para la salud.

La Administración Nacional de Medicamentos, Alimentos y Tecnología Médica (ANMAT) emitió una advertencia a la población tras detectar la bacteria Listeria monocytogenes en un lote puntual de queso Cremón doble crema de la marca La Serenísima.

El organismo de control emitió una alerta tras detectar Listeria en un lote de queso Cremón doble crema, recomendando no consumir el producto, especialmente si está fuera de fecha o congelado.

La Administración Nacional de Medicamentos, Alimentos y Tecnología Médica (ANMAT) emitió una advertencia a la población tras detectar la bacteria Listeria monocytogenes en un lote puntual de queso Cremón doble crema de la marca La Serenísima.
Si bien el producto ya superó su fecha de vencimiento, el organismo advirtió que aún podría representar un riesgo para quienes lo hayan conservado, especialmente mediante congelación.

La preocupación se centra principalmente en personas con sistemas inmunológicos debilitados y en mujeres embarazadas, para quienes la listeriosis puede derivar en complicaciones graves.
La detección surgió en el marco de la vigilancia genómica llevada adelante por el Laboratorio Nacional de Referencia de la Administración Nacional de Laboratorios e Institutos de Salud “Dr. Carlos G. Malbrán”. El análisis permitió identificar un grupo de casos asociados a muestras de queso de pasta blanda remitidas por el Servicio Nacional de Sanidad y Calidad Agroalimentaria (SENASA).

El informe técnico de SENASA, fechado el 9 de diciembre de 2025, precisó que la bacteria fue hallada en el queso Cremón doble crema de 500 gramos, lote 2703, elaborado el 3 de julio de 2025 y con vencimiento el 11 de septiembre de 2025. El producto fue fabricado por la empresa Mastellone Hnos. S.A. en su planta de Trenque Lauquen, provincia de Buenos Aires.
Bajo la supervisión de SENASA, la firma llevó adelante una investigación interna para identificar el origen de la contaminación y eliminar el foco detectado. Además, se procedió al retiro del lote afectado de todo el mercado nacional y a su posterior destrucción.
Como medida preventiva, se implementaron controles adicionales en los procesos productivos para evitar la repetición de situaciones similares.
La ANMAT recordó que la listeriosis es una enfermedad causada por el consumo de alimentos contaminados con Listeria monocytogenes, una bacteria presente en el agua y el suelo. Una de sus principales características es su capacidad para desarrollarse incluso a temperaturas de refrigeración, aunque puede eliminarse mediante una correcta cocción.
Los alimentos que con mayor frecuencia se asocian a brotes de esta enfermedad incluyen fiambres y embutidos, lácteos elaborados con leche no pasteurizada, vegetales crudos y pescados crudos o ahumados.
Los síntomas pueden variar desde manifestaciones leves como fiebre, escalofríos, cansancio, náuseas, vómitos, diarrea y dolor abdominal, hasta cuadros severos como meningitis o septicemia. En mujeres embarazadas, la infección puede provocar abortos, partos prematuros o complicaciones en el recién nacido.
El período de incubación puede extenderse hasta setenta días, con un promedio de aparición de síntomas a las tres semanas del contagio. Los grupos con mayor riesgo son embarazadas, recién nacidos, adultos mayores y personas inmunosuprimidas.
Recomendaciones para la población
La ANMAT recomendó a quienes tengan en su poder el queso Cremón doble crema, lote 2703, de 500 gramos —ya sea fraccionado o congelado— no consumirlo bajo ninguna circunstancia. También recordó la importancia de extremar las medidas de higiene al manipular alimentos, lavar adecuadamente frutas y verduras, y mantener limpios los utensilios de cocina.